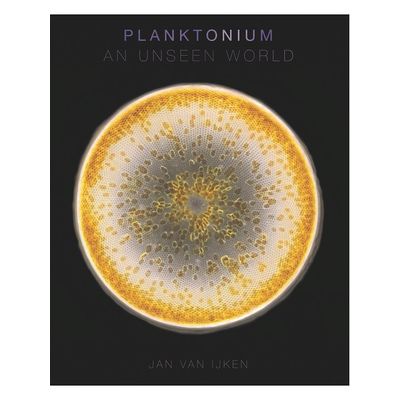
1168904.jpg

Ciências Biológicas
Se você está procurando livros sobre Ciências Biológicas, a Livraria Martins Fontes
Paulista é o lugar ideal para você!
Com uma ampla seleção de títulos de autores e editoras especializados, a Livraria
Martins Fontes Paulista é um verdadeiro paraíso para estudantes, pesquisadores e entusiastas
das ciências biológicas.
Em nossa loja, você encontrará livros que abrangem desde a biologia
molecular e até celular.
Nossos livros são cuidadosamente selecionados para atender às necessidades de todos os
níveis de conhecimento, desde iniciantes até especialistas.
Para os estudantes que buscam se aprofundar em biologia, temos livros didáticos
e guias
de estudo que oferecem uma visão geral clara e concisa dos principais conceitos e teorias da
biologia. Também temos livros que abordam temas específicos, como genética,
microbiologia e
botânica,
para aqueles que desejam se concentrar em áreas específicas de interesse.
Além disso, a Livraria Martins Fontes Paulista também oferece uma ampla seleção
de livros de referência e pesquisa para profissionais e pesquisadores em biologia. Nossos livros
são escritos por alguns dos principais especialistas do mundo em suas áreas de
atuação e oferecem informações atualizadas e de alta qualidade sobre os mais
avanços em pesquisa biológica.
Não importa se você é um estudante, um pesquisador ou um amante da biologia, a Livraria
Martins Fontes Paulista tem o livro perfeito para você.